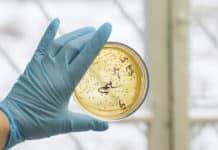
Immune System In a Petri Dish : Scientists Tweak Immune Cells To Speed Up Vaccine Development Project Fellow Position for MSc Biosciences @ Manipal University, Jaipur

Merck, Samsung Bioepis Biosimilar Launch Paves Way For Price War
Merck & Co and South Korea's Samsung Bioepis have announced the launch of their biosimilar of Remicade® (infliximab), the blockbuster immune-mediated inflammatory disorders treatment it...
Immune System In a Petri Dish : Scientists Tweak Immune Cells To Speed Up...
B cells are important immune cells. They produce antibodies against foreign molecules on pathogens, and in this way they protect us against disease. When...
PhD Admission Notification : 2017-18 @ Pune University
Pune University PhD Program
SAVITRIBAI PHULE PUNE UNIVERSITY
(Formerly University of Pune)
Notification
Ph.D. Entrance Examination 2017-18
Online Applications are invited by the Savitribai Phule Pune University from...
Govt Job : JRF Fellow, Biotech Post Vacant @ National Institute of Criminology and...
No 3/7/2014 LNJN NICFS
Government or India
Ministry of Home Affairs
LNJN National Institute of Criminology and Forensic Science
Institutional Area, Outer Ring Road, Sector-3. Rohini. Delhi...
RGCB Life Science PhD Admission Notification For – September 2017 Session
PhD ADMISSIONS - SEPTEMBER 2017
Advt No: RGCB/PhD/2017-II
Rajiv Gandhi Centre for Biotechnology (RGCB) invites application for admission to the PhD program (September 2017 session) in...
Biotecnika Times – Newsletter 25.07.2017
Govt Job : Food Safety Officer Post Vacant @ Govt of NCT of Delhi
Only online applications will be accepted. Applications received through any other...
The Plastic Age : The Great Pacific Garbage Patch
This is why cats hate us. (Don’t mind me. I am still trying to get over my feline-phobia)
So, somewhere in the North Pacific, there's...
Insulin Sprays To Curb Your Hunger Pangs
Dopamine is the most notorious celebrity of Brainsville. It is the Paris Hilton of the neurotransmitters.
Normally, when we see tasty food, our brain's reward...
Schrödinger, Takeda To Form Multiyear R&D Alliance
Japanese Pharma, Takeda, currently refocusing its R&D efforts on oncology, gastroenterology and central nervous system after overhaul announced last July has now penned a...
Cows Can Help in Discovery Of A Revolutionary HIV Vaccine !
Being addressed as a cow by my mum does not seem so bad now.
In what seemed to be an unexpected turn of events, scientists...
Dartmouth Researchers Bust the Achilles Heel of Cancer
Virtually all cancer treatments used today also damage normal cells, causing the toxic side effects associated with cancer treatment.
Now, a research team led by...
British Biotech To Acquire GE’s Gene Tech Arm
Cambridge based biotech Horizon Discovery, in a step towards its aim to become the world leader in human gene editing, has announced the acquisition...
4 PhD Fellowships Available @ University of Heidelberg, Germany
The new Research Training Group (RTG) “Elucidation of molecular mechanisms as foundation for an evidence-based complementary and integrative medicine” being set up at the...
Govt Job @ Karnataka State AIDS Prevention Society – M.sc Biotech / Microbiology /...
Department of Health & Family Welfare
KARNATAKA STATE AIDS PREVENTION SOCIETY
Sir. C.V. Raman General Hospital, 2nd Floor, 80 feet road, Indiranagar, Bengaluru.
No. KSAPS/BS/POSTS/14/2017-17
NOTIFICATION FOR WALK-IN-INTERVIEW
It...
Scientist Develops Bioinformatics Program To Study Intrinsically Disordered Proteins
Proteins are the building blocks of life; they are drivers of growth and development, the spread of viruses and bacteria, have key roles in...